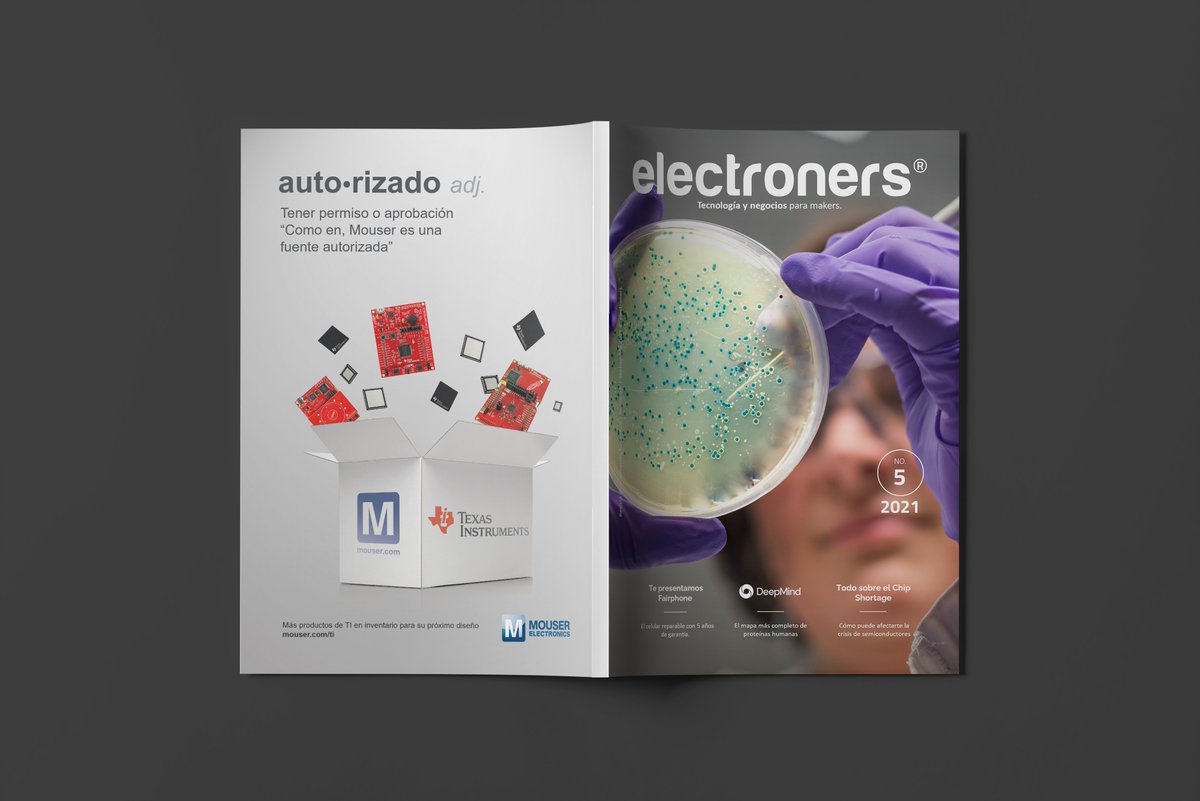
mcelive's tweet image. La edición de Septiembre de Electroners ya está disponible! Descargala gratis desde todos tus dispositivos. electroners.com/wp-content/upl…

Electroners
@mcelive
Tecnología y negocios para makers.
You might like
Descubra los productos de temporización y sincronización para aplicaciones militares 5G: electroners.com/descubra-los-p…

Las recetas médicas generan un nuevo interés en las soluciones de IoT para la gestión de píldoras: electroners.com/las-recetas-me…

La edición de Enero de Electroners ya está disponible! Descargala gratis desde todos tus dispositivos. electroners.com/wp-content/upl…

Aprendé más sobre el Nordic Semiconductor nPM1100 Power Management ICs y sus aplicaciones: @MouserElec mouser.com/new/nordic-sem…

No te pierdas toda la información de la #CES 2022, somos prensa autorizada en el evento de tecnología más importante del año. Mirá la cobertura especial en electroners.com y nuevos contenidos en electroners.mx

La edición de Noviembre de Electroners ya está disponible! Descargala gratis desde todos tus dispositivos. electroners.com/la-edicion-de-…

Nuevo Whitepaper: Por qué los módulos inteligentes simplifican el desarrollo, aceleran el tiempo de comercialización y hacen posible la escalabilidad de IoT. quectel.com/library/why-sm…

Soluciones robustas para industria pesada. Optimice sus operaciones con sensores y módulos especializados. electroners.com/soluciones-rob…

Showcase: Soluciones para la industria de Microchip Technology. electroners.com/soluciones-par…

Nuevas soluciones de Microchip para carga de vehículos eléctricos (OBC) electroners.com/soluciones-de-…

No te pierdas este lanzamiento en Mouser Electronics Maxim Integrated MAX17701 Supercapacitor Charger Controller: mouser.com/new/maxim-inte…

La edición de Septiembre de Electroners ya está disponible! Descargala gratis desde todos tus dispositivos. electroners.com/wp-content/upl…
Presentamos la nueva cámara Time-of-Flight de STMicroelectronics mouser.com/new/stmicroele…

Google compra DeepMind una empresa de AI aplicada a resolución de estructuras de proteínas. electroners.com/google-compra-…

Monitoreo ambiental. Soluciones confiables para el monitoreo de variables en smart cities. @MouserElec

Inteligencia Artificial de borde para aplicaciones en tiempo real. mouser.com/empowering-inn…

United States Trends
- 1. #USAHockey N/A
- 2. #bucciovertimechallenge N/A
- 3. Canada N/A
- 4. Hellebuyck N/A
- 5. #Olympics2026 N/A
- 6. Jack Hughes N/A
- 7. Team USA N/A
- 8. McDavid N/A
- 9. Mar-a-Lago N/A
- 10. MacKinnon N/A
- 11. 3 OT N/A
- 12. Matthews N/A
- 13. Go USA N/A
- 14. Tom Wilson N/A
- 15. Boldy N/A
- 16. Secret Service N/A
- 17. John Barron N/A
- 18. Makar N/A
- 19. Mike Sullivan N/A
- 20. Sam Bennett N/A
Something went wrong.
Something went wrong.










































































































